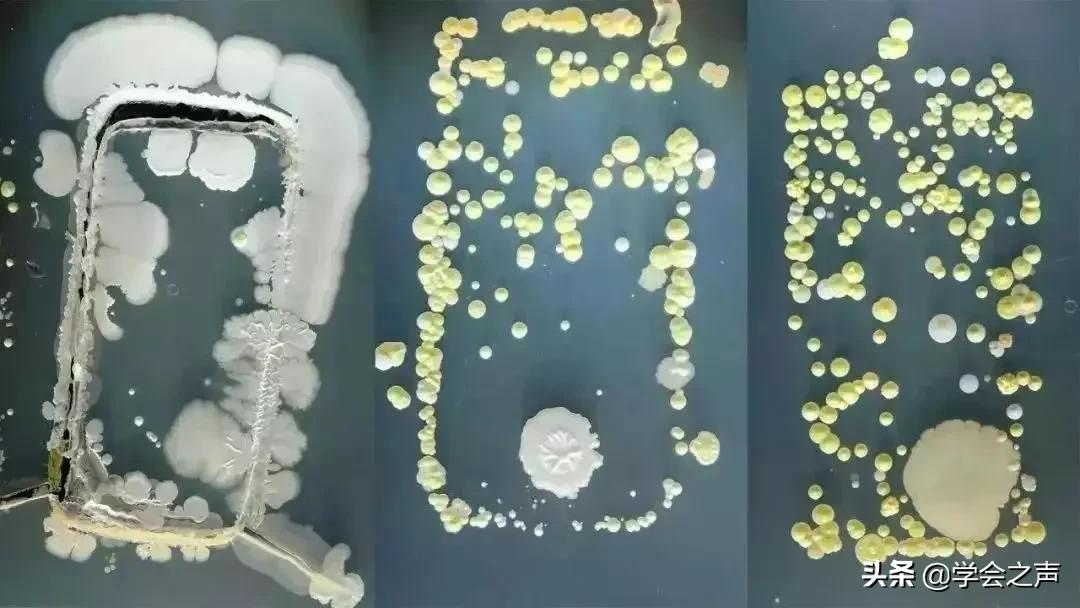
科学防疫手机消毒很有必要,疫情期间怎么给手机杀菌消毒

被“困”在家,手机一定已经成了你“形影不离”的伙伴。看看新闻,和朋友聊上两句,再刷刷朋友圈……甚至上个厕所都带着手机。
据统计每人平均每天会点击手机屏幕2600多次,可能附着2000多种细菌,1/4的手机细菌总数超过正常值的10倍。最常见的是大肠杆菌及金黄色葡萄球菌,沙门氏菌、流感病毒等病菌也占比较大。
虽然在其他方面做足了各种防护工作,但这个“隐形”的卫生死角却偏偏被遗忘了!这个被你天天捧在手上的“细菌窝”消毒了吗?
如何避免手机变成细菌窝?
方法
01
勤快消毒法
出门使用手机或有可疑接触后,建议给手机做一次消毒。可以使用专业的手机消毒剂,或者用棉球蘸取酒精进行消毒。
如何正确 为 手机消毒
1
给手机消毒时,应先用洗洁精去除手机表面油脂;
2
用棉球蘸取医用酒精(浓度为75%),或直接用酒精消毒棉片,直接擦拭消毒;
3
轻轻用其擦拭手机表面两遍,除了手机正反两面外,不要忽略了听筒、话筒、耳机孔、充电接线孔以及手机的边缝接合处等;
4
消毒过程中,要按一个方向擦拭,不要来回擦,正反两面各擦两遍;
5
5、如有手机壳也要脱下来单独擦拭,手机壳内部也要不留死角。
方法
02
日常清洁法
上面所说的是针对特殊时期的手机消毒方法,在平时的日常生活中只要用细纤维眼镜布+沾少量眼镜洗液进行擦拭就能对手机进行清洁啦~
消毒时要注意
1
在用酒精棉球为手机等、平板电脑等电子设备消毒时,一定要将酒精棉球中多余的酒精挤出,使棉球处于刚好湿润但又不会滴下酒精来,以防酒精流入手机内部,造成手机故障;
2
因酒精属于易挥发且易燃的物品,所以在消毒过程中一定要远离明火和容易产生静电处。为电子设备消毒时,切记一定要拔掉正在充电的电源,以免引发意外;
3
84消毒液虽能起到消毒的效果,但它对金属物品具有腐蚀性,所以并不适合用于给手机消毒。

方法
03
减少外出时使用
虽说特殊时期,我们提倡尽量避免外出。但当必须出门时,希望你能做到少拿出手机使用,因为难免会碰触扶手、电梯按钮、门帘、购物车等公共部位。如果在外使用了手机,回家除了洗手,记得也要清洁一下手机。
方法
04
不外借
手机尽量不要外借,以避免交叉传染病毒。同样,也不要对别人的手机指指点点,因为你也不知道别人手机上都有着哪些细菌或病毒。

方法
05
不带着上厕所
上厕所玩手机,手机也可能被污染,就算便后洗手,当再接触手机,手又会被污染。所以,如果你在如厕时将用过手机或将手机带入过厕所,建议立刻对手机进行消毒,以防病菌传播。
方法
06
公共交通上别玩
手接触公交扶手再去玩手机,手机会被污染,如果回家只洗手不清理手机,风险依然存在。所以,在公交或地铁上不妨放下手机,选择闭目养神吧。

方法
07
吃饭时别玩
在吃饭时玩手机,就算手洗得再干净,也会在玩手机时重新被附着在手机上的病原体所污染,从而在吃饭时接触到食物而进入体内。所以,吃饭时还是认认真真吃好饭,就别看手机了。